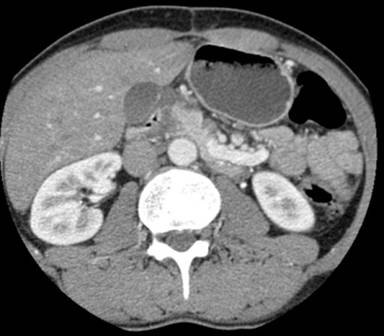

CASE SERIES
JOP. J Pancreas (Online) 2011 May 6; 12(3):230-233.
Groove Pancreatitis. A Mini-Series Report and Review of the Literature
Antonio Manzelli, Athanasios Petrou, Alesandra Lazzaro, Nicholas Brennan, Zahir Soonawalla, Peter Friend
Department of Hepatobiliary Surgery, Surgery and Diagnostics Centre, Churchill Hospital. Headington, Oxford, United Kingdom
ABSTRACT
Context Groove pancreatitis is a rare condition characterized by fibrotic inflammation affecting the groove anatomical area between the head of the pancreas, the duodenum and the common bile duct. Objectives We report a miniseries of five cases treated surgically in our centre over a period of four years. A review of the literature is also discussed. Methods Patients undergoing pancreaticoduodenectomy over a four-year period were retrospectively reviewed. Patients with a confirmed histological diagnosis of groove pancreatitis were assessed under the headings; patient demographics, presenting symptoms, radiological and histological findings. Results One-hundred and 60 pancreaticoduodenectomies were performed. Thirty-nine cases demonstrated benign disease and within this, five cases (3.1% of total series; 12.8% of benign cases) were groove pancreatitis. All patients presented with abdominal pain and weight loss, and the majority consumed excess alcohol and were smokers. Radiological findings (CT/MRCP/EUS) revealed duodenal wall thickening in all cases, abnormalities at the head of pancreas and bile duct dilation in four, and cystic changes in the duodenal wall and pancreatic duct dilation in three cases. Groove fibrosis, Brunner’s gland hyperplasia and cystic changes in duodenal wall were present in all cases on histological review. All patients reported significant improvement in quality of life at 12 months after surgery. Conclusion Groove pancreatitis can present in a similar fashion to head of pancreas cancer and chronic pancreatitis. For this reason it is paramount for clinicians to be aware of groove pancreatitis, as this can lead to the correct diagnosis and management of this unique disease.
INTRODUCTION
Groove pancreatitis is a rare condition consisting of a segmental chronic pancreatitis affecting the pancreatoduodenal groove which is described as a potential space bordered by the head of the pancreas, duodenum, and common bile duct [1, 2, 3, 4]. Groove pancreatitis presents more frequently in males, in their fourth and fifth decade, with moderate or severe alcohol history and with symptoms of chronic postprandial epigastric pain, nausea, vomiting and significant weight loss. Differentiating on clinical and radiological grounds between groove pancreatitis and peripancreatic head cancers can be extremely challenging. The pathogenesis of groove pancreatitis remains controversial and unclear despite increased exposure in the literature. Current theories centre on pancreatic outflow obstruction at the Santorini duct but several other factors may be important: peptic ulcers, gastric resection, true duodenal-wall cysts, and pancreatic heterotopia in the duodenal wall [3, 4]. We report a miniseries of five cases treated surgically in our centre over a period of four years.
MATERIALS AND METHODS
Patients undergoing pancreaticoduodenectomy over a four-year period (June 2006 to June 2010) at a large tertiary centre for hepatobiliary and pancreatic surgery in Oxford, United Kingdom were retrospectively reviewed. The indications for surgery included suspected carcinoma of the head of pancreas, chronic pancreatitis and carcinoma of the ampulla of Vater. All patients were extensively investigated (CT, MRI, ERCP, MRCP or EUS) before surgical intervention was deemed necessary. In all five cases groove pancreatitis was part of the differential diagnosis based on radiological findings alone and in all cases was confirmed by histological analysis. The key pathological criteria for diagnosis included: 1) dilated ducts and pseudocystic changes in the duodenal wall; 2) Brunner’s gland hyperplasia; 3) fibrosis in the adjacent pancreas and soft tissue, especially in the “groove” area.
Patients with a confirmed histological diagnosis of groove pancreatitis were assessed under the headings patient demographics, presenting symptoms, radiological and histological findings (Table 1). At six- and twelve-month follow a 12-item Short Form Health Survey (SF-12) was used to assess quality of life.
|
Table 1. Patient demographics and primary symptoms during course of groove pancreatitis. |
||||||
|
Case |
Age (years) |
Gender |
Symptoms |
Diabetes |
Excess alcohol |
Smoker |
|
#1 |
39 |
Male |
Abdominal pain, weight loss, steatorrhea |
No |
Yes |
Yes |
|
#2 |
50 |
Female |
Abdominal pain, weight loss, nausea |
No |
Yes |
Yes |
|
#3 |
54 |
Female |
Abdominal pain, weight loss, nausea |
No |
Yes |
Yes |
|
#4 |
60 |
Female |
Abdominal pain, weight loss, steatorrhea |
Yes |
No |
No |
|
#5 |
70 |
Male |
Abdominal pain, weight loss, steatorrhea |
No |
Yes |
Yes |
Excess alcohol defined as more than 30 unit/week
RESULTS
There were 160 pancreaticoduodenectomies performed over a four-year period. Thirty-nine cases (24.4%) revealed benign pancreatic disease and five cases (3.1% of total series; 12.8% of benign cases) demonstrated groove pancreatitis. There were three females and two males with a mean age of 54 years with a range between 39 and 70 years. All patients with groove pancreatitis presented with persistent abdominal pain and weight loss. The majority of these patients (four) consumed excess alcohol (defined as more than 30 unit/week) and were smokers. Exocrine pancreatic deficiency and weight loss were noted in all patients and steatorrhea in three cases. One patient was diabetic and another presented with jaundice.
All five patients underwent an initial abdominal CT scan. Three patients had subsequent imaging with MRCP or EUS and one patient had both. In all cases duodenal wall thickening was present. Four patients showed changes at the pancreatic head, either an ill-defined mass or a swollen head of pancreas (Figure 1). Bile duct dilation was noted in four of the five cases. MRI and EUS observations correlated well with CT findings providing additional information in all cases: pancreatic duct dilation, duodenal wall thickening and bile duct dilation.
|
Figure 1. Contrast enhanced CT scan demonstrating an ill-defined hypoechoic mass in the head of the pancreas. |
On histological review, all five cases showed signs of chronic inflammation with fibrotic changes at the anatomical groove area between the head of the pancreas, the duodenum and the common bile duct. Two cases also demonstrated inflammatory changes at the head of the pancreas in keeping with segmental groove pancreatitis with the remaining three labeled pure groove pancreatitis. Cystic changes in the duodenal wall were present in all cases (Table 2). These cysts were embedded in the smooth muscle or fibrous tissue. The quantity of cysts varied from one to six and the size ranged from 0.3 to 2.1 cm. Groove fibrosis and Brunner’s gland hyperplasia were also demonstrated in all cases. In three cases clusters of ectopic pancreatic lobules were reported. In these instances, pancreatic acini and ducts were noted in the muscle layer, and submucosa of the duodenal wall adjacent to the ampulla.
|
Table 2. Radiological and histopathological findings. |
||||
|
Case |
CT |
MRCP |
EUS |
Histology |
|
#1 |
Duodenal wall thickening, chronic pancreatitis, cystic changes duodenal wall |
Cystic changes duodenal wall, duodenal wall thickening, pancreatic duct dilation, biliary duct dilation |
Not done |
Cystic changes duodenal wall, groove fibrosis, Brunner’s gland hyperplasia, ectopic pancreatic tissue, pancreatic duct dilation |
|
#2 |
Duodenal wall thickening, 3cm mass head of pancreas, cystic changes duodenal wall |
Not done |
Duodenal wall thickening, swollen head of pancreas, biliary duct dilation, mass head of pancreas , cystic changes duodenal wall |
Cystic changes duodenal wall, groove fibrosis, Brunner’s gland hyperplasia, biliary duct dilation, ectopic pancreatic tissue |
|
#3 |
Duodenal wall thickening, biliary duct dilation |
Biliary duct dilation, pancreatic duct dilation, duodenal wall thickening |
Not done |
Cystic changes duodenal wall, groove fibrosis, Brunner’s gland hyperplasia, pancreatic duct dilation |
|
#4 |
Cystic mass head of pancreas (3 cm), chronic pancreatitis |
Cystic mass head of pancreas (2.5 cm), duodenal wall thickening |
Duodenal wall thickening, swollen head of pancreas, cystic changes duodenal wall |
Cystic changes duodenal wall groove fibrosis, Brunner’s gland hyperplasia, ectopic pancreatic tissue |
|
#5 |
Duodenal wall thickening, cystic changes duodenal wall, biliary duct dilation |
Not done |
Duodenal wall thickening, cystic changes duodenal wall, pancreatic duct dilation, swollen head of pancreas, biliary duct dilation |
Cystic changes duodenal wall, groove fibrosis, Brunner’s gland hyperplasia, biliary duct dilation |
After consideration of the available assessment tools the 12-item Short Form Health Survey (SF-12) was used to assess quality of life. All five patients reported cessation or reduction in analgesia, weight gain and significant improvement in preoperative symptoms and overall quality of life at 12 months after surgery.
DISCUSSION
The first description resembling groove pancreatitis was by Potet and Duclert in 1970 as cystic dystrophy of the pancreas [5] and later in the German literature by Becker in 1973 as ‘‘segmentare pankreatitis’’[6]. Stolte et al. later identified the features of groove pancreatitis in 30 histological specimens obtained from 123 pancreaticoduodenectomies [1]. Stolte et al. defined ‘‘groove pancreatitis’’ as a special form of segmental pancreatitis characterized by fibrous scars of the anatomic space between the dorsocranial part of the head of the pancreas, the duodenum, and the common bile duct [1]. Becker and Mischke recognized different types of groove pancreatitis: a “pure” form were only the anatomical groove was involved; a “segmental” form in which the scarring affects the dorsocranial portion of the pancreatic head; and a “non-segmental” form with a chronic homogenous pancreatitis in addition to groove involvement [7]. More recently Adsay and Zamboni have grouped groove pancreatitis, with cystic dystrophy of the pancreas, pancreatic hamartoma of duodenum, paraduodenal wall cyst and myoadenomatosis, and propose a universal name referred to as “paraduodenal pancreatitis” [8].
Despite increased exposure in the literature, the reported prevalence varies greatly with rates varying from 2.7%, 19.5%, and 24.5% in three large series of pancreaticoduodenectomies for chronic pancreatitis [1, 2, 3, 8]. In our series the rate was 3.1%. Patients most frequently present in their fourth and fifth decade, with symptoms of long stand postprandial epigastric pain, radiating to the back, associated with nausea, vomiting and weight loss. Blood tests often show deranged pancreatic enzymes and occasionally abnormal liver function tests without clinical evidence of jaundice [4].
Differentiating groove pancreatitis and peripancreatic head cancers or more specifically adenocarcinoma of the head of the pancreas remains a diagnostic challenge. Typically abdominal ultrasound shows a hypoechoic mass whereas CT scans often reveal a hypodense, poorly enhanced mass between the head of the pancreas and the thickened duodenal wall [10]. Additional imaging with MRCP, EUS and/or ERCP is essential in further differentiating groove pancreatitis from head of pancreas cancers [10, 11, 12, 13]. MRI shows soft-tissue-attenuation images with delayed enhancement reflecting the fibrous nature noted between the pancreatic head and the adjacent duodenum. Irie et al. describes a plate like mass in the pancreatoduodenal groove that was hypointense relative to the pancreatic parenchyma on T1-weighted MRI images and isointense or slightly hyperintense on T2-weighted MRI [3]. EUS and ERCP often reveal smooth tubular stenosis of the common bile duct and irregularity and dilatation of the main pancreatic duct and its branches. Obstructive jaundice is rarely found in groove pancreatitis unlike adenocarcinoma of the head of the pancreas or distal common bile duct. Having an experienced operator performing the EUS, CT and MRI cannot be overstated. Overall, the most well characterized radiological findings are cystic lesions in the duodenal wall, duodenal wall thickening and a poorly enhanced mass between the head of the pancreas and the thickened duodenal wall [9, 13, 14]. In our series this was demonstrated in all five patients.
The pathogenesis of groove pancreatitis remains poorly defined with disturbances of pancreatic outflow through the Santorini duct (minor papilla) the most well established. Here it is postulated that chronic alcohol intake and/or smoking increases the viscosity of the pancreatic juice leading to pancreatic duct calcification and subsequent outflow obstruction of the pancreatic juices [3, 4]. Hyperplasia of the Brunner’s glands, possibly secondary to increased cholecystokinin-pancreozymin or gastrin levels may also lead to stasis of pancreatic juices in the dorsal pancreas and result in pancreatitis at the anatomical groove [3, 4]. Other factors such as fibrous scarring secondary to peptic ulcers, gastric and duodenal resections or true duodenal-wall cysts may also be related [3].
In many instances resection is often performed as the diagnosis of groove pancreatitis is unclear. However, with an increased understanding in the radiological findings, initial non-surgical treatments are more frequently employed. These conservative options involve cessation of smoking and alcohol, adequate analgesia, resting the pancreas and in some instances endoscopic stenting of the minor papilla. However, these measures are only temporary and surgery is inevitable when symptoms fail to improve or, in many cases, when there is uncertainty over the diagnosis. Pancreaticoduodenectomy or pylorus-preserving pancreaticoduodenectomy offer a curative treatment for groove pancreatitis with complete resolution of symptoms in most cases [1]. Histopathological assessment of the resected specimen reveals characteristic fibrous scarring and thickening of the duodenal wall between the duodenal lumen and the pancreas.
The macro- and microscopic features of groove pancreatitis are quite similar to those reported for cystic dystrophy of the duodenal wall [1, 2, 3, 4]. Cystic dystrophy of the duodenal wall, an entity that is most likely related to groove pancreatitis, is characterized by the presence of cystic lesions in the thickened wall of the second portion of the duodenum. Other important histopathological findings in groove pancreatitis include groove fibrosis, Brunner’s gland hyperplasia and ectopic pancreatic tissue in the duodenal wall.
CONCLUSION
Groove pancreatitis is a unique disease which can present with symptoms suggestive of pancreatic cancer. In our series the diagnosis of groove pancreatitis was identified in 4 out of 5 cases based on clinical symptoms and radiological findings alone. The most important of these findings are cystic lesions in the duodenal wall, duodenal wall thickening and a poorly enhanced mass between the head of the pancreas and the thickened duodenal wall. Pancreaticoduodenectomy can be curative with complete resolution of symptoms in many. Overall, it is paramount for clinicians to be aware of groove pancreatitis, as this can lead to the correct diagnosis and management of this unique condition.
Received January 20th, 2011 - Accepted February 11th, 2011
Conflict of interest The authors have no potential conflict of interest
Correspondence
Nicholas Brennan
16 Ashlawn, Ballinteer Road
Dublin 16
Ireland
Phone: +353-1.296.0006; +44-785.224.7928
Fax: +353-1.296.0006
E-mail: nicky_brennan@hotmail.com
References
1. Stolte M, Weiss W, Volkholz H, Rosch W. A special form of segmental pancreatitis: groove pancreatitis. Hepatogastroenterology 1982; 29:198-208. [PMID 7173808]
2. Becker V, Bauchspeichel D. Spezielle Pathologische Anatomic Bd. VI. In: Doerr W, Seifert G, Uhlinger E, Eds. Springer, Berlin-Heidelberg-New York, 1973.
3. Irie H, Honda H, Kuroiwa T, Hanada K, Yoshimitsu K, Tajima T, et al. MRI of groove pancreatitis. J Comput Assist Tomogr 1998; 22:651-5. [PMID 9676462]
4. Itoh S, Yamakawa K, Shimamoto K, Endo T, Ishigaki T. CT findings in groove pancreatitis: correlation with histopathological findings. J Comput Assist Tomogr 1994; 18:911-5. [PMID 7962798]
5. Potet F, Duclert N. Cystic dystrophy on aberrant pancreas of the duodenal wall. Arch Fr Mal App Dig 1970; 59:223-38. [PMID 5419209]
6. Becker V. Proceedings: Fundamental morphological aspects of acute and chronic pancreatitis (author's transl). Langenbecks Arch Surg 1973; 334:317-22. [PMID 4776105]
7. Becker V, Mischke U. Groove pancreatitis. Int J Pancreatol 1991; 10:173-82. [PMID 1787332]
8. Adsay NV, Zamboni G. Paraduodenal pancreatitis: a clinico-pathologically distinct entity unifying 'cystic dystrophy of heterotopic pancreas', 'para-duodenal wall cyst', and 'groove pancreatitis'. Semin Diagn Pathol 2004; 21:247-54. [PMID 16273943]
9. Yamaguchi K, Tanaka M. Groove pancreatitis masquerading as pancreatic carcinoma. Am J Surg 1992; 163:312-6. [PMID 1539765]
10. Gabata T, Kadoya M, Terayama N, Sanada J, Kobayashi S, Matsui O. Groove pancreatic carcinomas: radiological and pathological findings. Eur Radiol 2003; 13:1679-84. [PMID 12835985]
11. Tio TL, Luiken GJ, Tytgat GN. Endosonography of groove pancreatitis. Endoscopy 1991; 23:291-3 [PMID 1743134]
12. Rahman SH, Verbeke CS, Gomez D, McMahon MJ, Menon KV. Pancreatico-duodenectomy for complicated groove pancreatitis. HPB (Oxford) 2007 ;9:229-34. [PMID 18333228]
13. Fléjou JF, Potet F, Molas G, Bernades P, Amouyal P, Fékété F. Cystic dystrophy of the gastric and duodenal wall developing in heterotopic pancreas: an unrecognised entity. Gut 1993; 34:343-7. [PMID 8097180]
14. Lai EC, Tompkins RK. Heterotopic pancreas. Review of a 26 year experience. Am J Surg 1986; 151:697-700. [PMID 3717502]